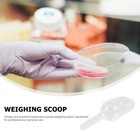
Bild 9 von 12

Bild 1 von 12

Galerie
Bild 1 von 12












Ähnlichen Artikel verkaufen?
1 Stück Glas Probenahme Wiegelöffel Labor Wiegen Halter Schaufeln
US $13,99
Ca.CHF 11,26
Artikelzustand:
10 verfügbar
Oops! Looks like we're having trouble connecting to our server.
Refresh your browser window to try again.
Rücknahme:
30 Tage Rückgabe. Käufer zahlt Rückversand. Wenn Sie ein eBay-Versandetikett verwenden, werden die Kosten dafür von Ihrer Rückerstattung abgezogen.
Zahlungen:
Sicher einkaufen
Der Verkäufer ist für dieses Angebot verantwortlich.
eBay-Artikelnr.:286896254050
Artikelmerkmale
- Artikelzustand
- Brand
- Unbranded
- MPN
- Does Not Apply
- UPC
- Does not apply
Artikelbeschreibung des Verkäufers
Informationen zur Produktsicherheit und Barrierefreiheit
Info zu diesem Verkäufer
qiyianhien
98,8% positive Bewertungen•670 Artikel verkauft
Angemeldet als gewerblicher Verkäufer
Verkäuferbewertungen (184)
- d***w- Bewertung vom Käufer.Letzte 6 MonateBestätigter KaufEven though I did get a bad blue ray player I have bought a lot of very nice things off this company with my other accounts. They promised me a refund so it's all good. I bought the cheapest blue ray player I could find and I think even they knew it wasn't likely that good of a product. But one bad buy is to be expected when you buy things all the time and I have bought a lot of stuff. So it's cool.External Drives Usb Bluray Dvd Player for Laptop Burner Plug and Type C . (Nr. 286498475670)
- m***m (1419)- Bewertung vom Käufer.Letztes JahrBestätigter KaufPackage arrived safe and secure. This dealer went out of their way to provide excellent communication when delivery was delayed by inclement weather. I was impressed. The quality of the dropper bottles should work very well for my project. Thank you for having these available.24pcs Squeezable Dropper Bottles Travel Empty Eye Liquid Bottles Dropper Bottles (Nr. 286460792648)
- i***s (2599)- Bewertung vom Käufer.Letzte 6 MonateBestätigter KaufFast shipping and as described; Good deal and what I needed at a reasonable price. Thanks, {\0/}10pcs Useful Portable Soccer Cones Player Outdoor Playground (Nr. 286389715564)
Noch mehr entdecken:
- Labor-Reagenzgläser aus Glas,
- Labor-Flaschen aus Glas,
- Markenlose Labor-Reagenzgläser aus Glas,
- Labor-Kolben & -Zylinder aus Glas,
- Labor-Bechergläser & -Messbecher aus Glas,
- Labor-Stereomikroskope,
- Labor-Zentrifugen,
- Sonstige Labor-Mikroskope,
- ZEISS Labor-Stereomikroskope,
- Labor-Objektive für Mikroskope ZEISS